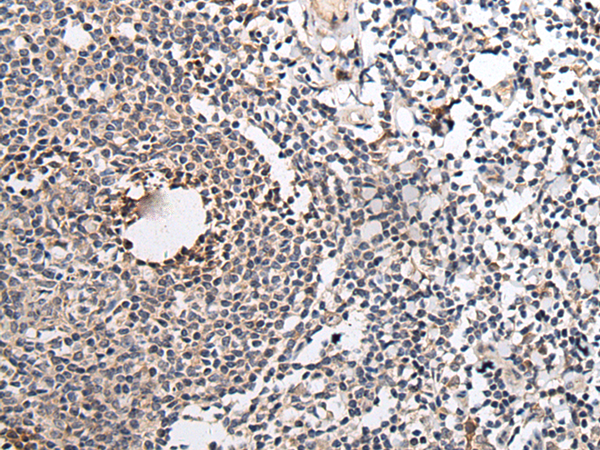
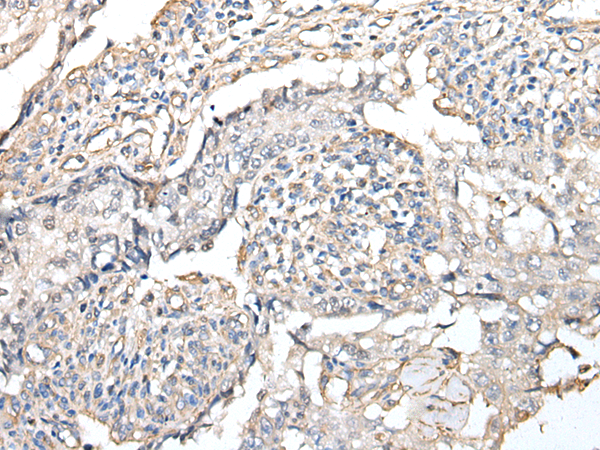

-
分类: 科研抗体货号: P12713别名: HSULF-2应用: IHC反应种属: Human, Mouse
-
分类: 科研抗体货号: P12693别名: NCX1应用: IHC反应种属: Human, Mouse, Rat
-
分类: 科研抗体货号: P12712别名: NCC; TSC; NCCT应用: IHC反应种属: Human, Mouse
-
分类: 科研抗体货号: P12692别名: AGC1; SEDK; AGCAN; CSPG1; MSK16; CSPGCP应用: IHC反应种属: Human
-
分类: 科研抗体货号: P12709别名: ACID2; PTOV-1应用: WB,IHC反应种属: Human, Mouse, Rat
-
分类: 科研抗体货号: P12691别名: KOG1; Mip1应用: IHC反应种属: Human, Mouse
-
分类: 科研抗体货号: P12708别名: PK1; PRK1; EGVEGF应用: IHC反应种属: Human, Mouse, Rat
-
分类: 科研抗体货号: P12719别名: HM2应用: WB反应种属: Human, Mouse, Rat
-
分类: 科研抗体货号: P12707别名: MTND5; ND5应用: IHC反应种属: Human
-
分类: 科研抗体货号: P12718别名: MEAI; SCG2应用: WB,IHC反应种属: Human, Mouse, Rat

鄂公网安备42018502007531号
鄂公网安备42018502007531号

